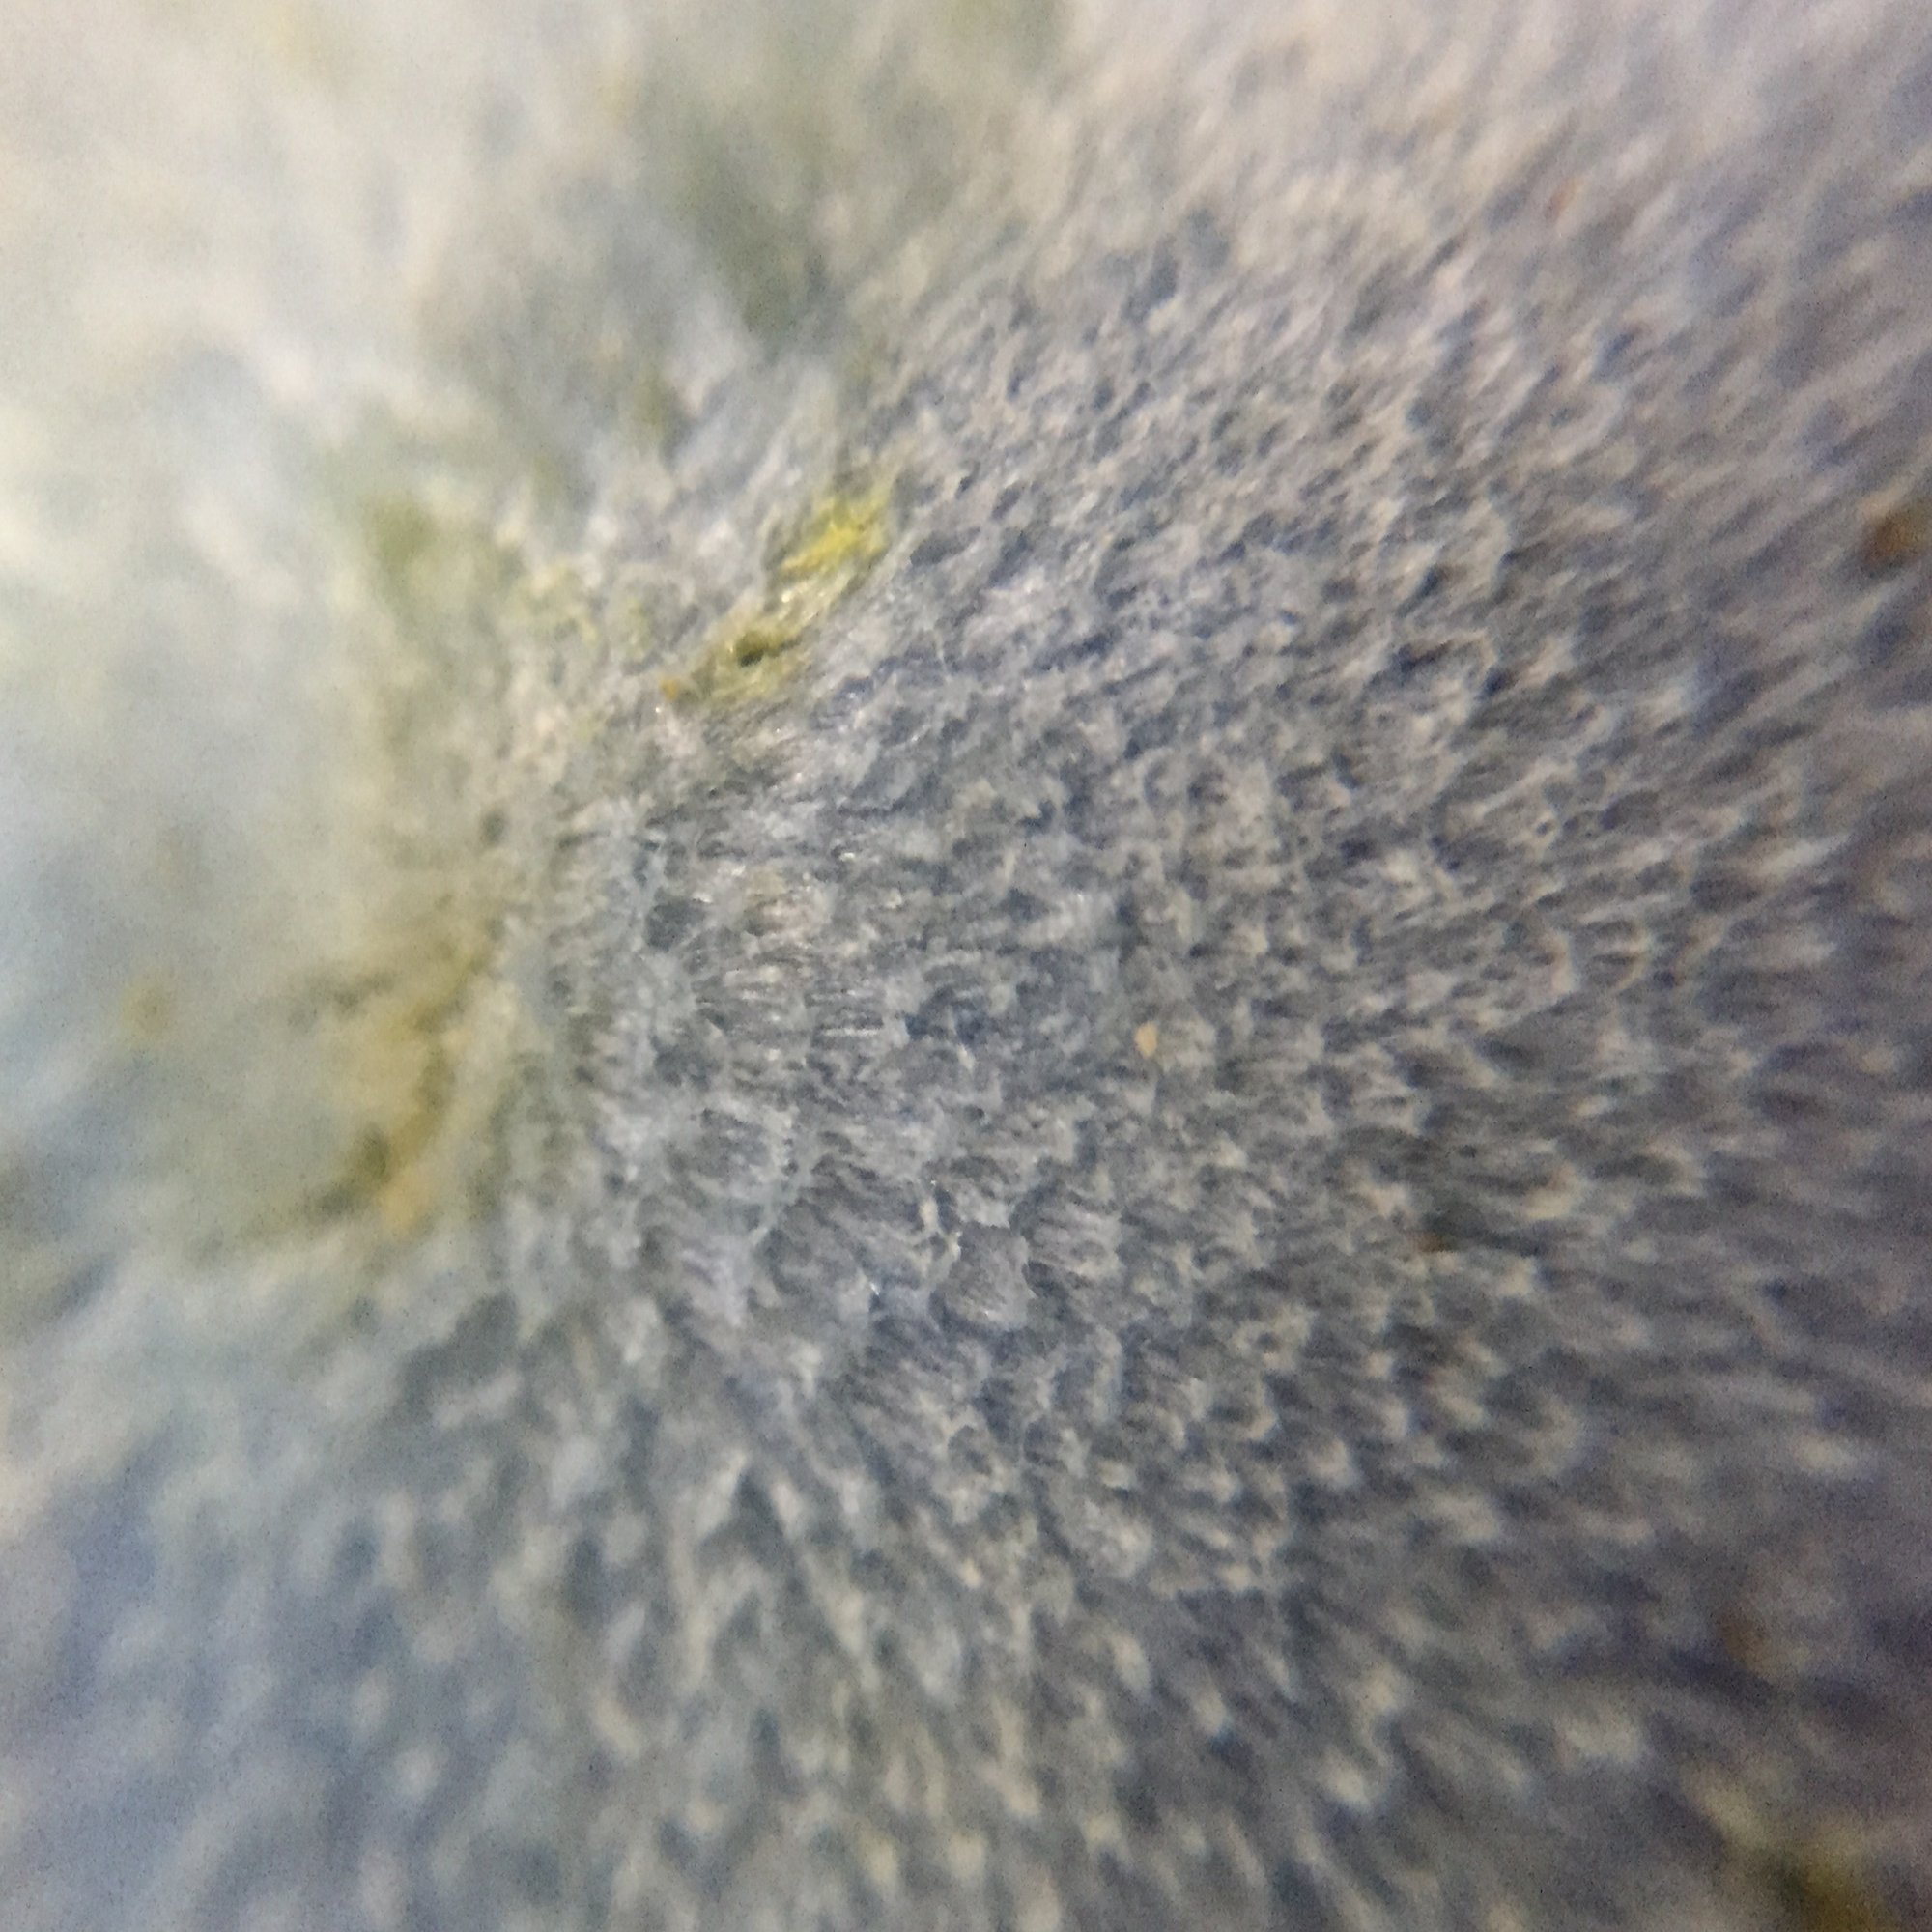

ソライロタケ(空色茸)Entoloma virescens
時期
夏~秋に発生します。(福岡県では6月~10月に観察することができます)
発生環境
広葉樹林・針葉樹林・竹林など意外と様々な場所で発見例がありますが、あまり見られないきのこです。

広葉樹林内に発生したソライロタケ。
特徴

全体が鮮やかな空色をしたきのこで、傘の表面は雲がかかっているかのように白い微毛でおおわれています。

子実体や菌糸は傷をつけると黄色く変色します。



ソライロタケは小笠原諸島のサンプルを基に1854年に新種記載されました。日本全国に分布するきのこですが、その姿をみることは容易ではなく、福岡県内でもごく稀にしか見られない珍しいきのこです。ただし、タイプ山地である小笠原諸島では多く観察されるようです。とても不思議です…。
漫画「さすらいのきのこ」






■前回の物語「キイボカサタケ」はこちら
【参考・サイト】
山渓カラー名鑑 増補改訂新版日本のきのこ(山と渓谷社)
しっかり見分け観察を楽しむきのこ図鑑(ナツメ社)
日本の生物多様性ホットスポットの構造に関する研究(国立科学博物館)
Facebook コメント


